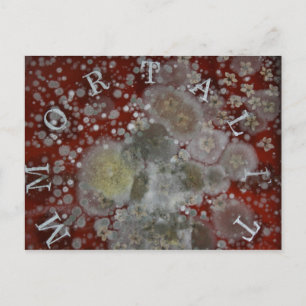
Unsterblichkeit Postkarte

Beliebte Religion Postkarten
5.907 Ergebnisse
Das Fürstgebet Postkarte
Sale Preis 1,70 €. Originalpreis 1,99 €.
Ein Blutspender Rettete mein Leben Christlich Postkarte
Sale Preis 1,65 €. Originalpreis 1,93 €.
Erstelle selbst! postkarte
Sale Preis 1,70 €. Originalpreis 1,99 €.
Gesegnete Jungfrau Mary, weiße Spitze, marineblau Postkarte
Sale Preis 1,74 €. Originalpreis 2,04 €.
Pantheon-Heiligtempel in Rom - Italien, Europa Postkarte
Sale Preis 1,60 €. Originalpreis 1,88 €.
Registerplatz - Samarkand, Usbekistan, Asien Postkarte
Sale Preis 1,60 €. Originalpreis 1,88 €.
Individualisierbarer Boho Islamischer Eid Mubarak Feiertagspostkarte
Sale Preis 1,32 €. Originalpreis 1,55 €.
Taufe Christi Postkarte
Sale Preis 1,65 €. Originalpreis 1,93 €.
Die Herrlichkeit Gottes wird offenbart werden Isai Postkarte
Sale Preis 1,83 €. Originalpreis 2,15 €.
Christ der Erlöser Postkarte
Sale Preis 1,88 €. Originalpreis 2,21 €.
Gebetsräder Postkarte
Sale Preis 1,70 €. Originalpreis 1,99 €.
Abtei Maria Laach, Eifel, Deutschland Postkarte
Sale Preis 1,65 €. Originalpreis 1,93 €.
Rumänien Postkarte
Sale Preis 1,65 €. Originalpreis 1,93 €.
Altes Rugkreuzgekreuzt Postkarte
Sale Preis 1,65 €. Originalpreis 1,93 €.
Weihnachtskathedralfenster Postkarte
Sale Preis 1,65 €. Originalpreis 1,93 €.
Rochester Cathedral Ansichtskarte Postkarte
Sale Preis 1,88 €. Originalpreis 2,21 €.
Unsterblichkeit 2 postkarte
Sale Preis 1,70 €. Originalpreis 1,99 €.
Unsterblichkeit Postkarte
Sale Preis 1,70 €. Originalpreis 1,99 €.
Weltfrieden mit religiösen Symbolen Postkarte
Sale Preis 1,65 €. Originalpreis 1,93 €.
Gott ist gut... Die ganze Zeit Christlich Postkarte
Sale Preis 1,65 €. Originalpreis 1,93 €.
Funny Sessings & Faith Spaß Postcard Postkarte
Sale Preis 1,70 €. Originalpreis 1,99 €.
Der Glaube und der Liebe des Lebens Postkarte
Sale Preis 1,55 €. Originalpreis 1,82 €.
Postkarte "Das letzte Abendessen"
Sale Preis 1,65 €. Originalpreis 1,93 €.
Jean-Francois Millet - Der Flug nach Ägypten Postkarte
Sale Preis 1,60 €. Originalpreis 1,88 €.
Ikon der Jungfrau Maria und des Kindes Jesus Postkarte
Sale Preis 1,65 €. Originalpreis 1,93 €.
Baby Jesus Postkarte
Sale Preis 1,74 €. Originalpreis 2,04 €.
Saint Michael der Erzengel Postkarte
Sale Preis 1,74 €. Originalpreis 2,04 €.
Tintern Abbey View Postkarte
Sale Preis 1,88 €. Originalpreis 2,21 €.
Bildung Postkarte
Sale Preis 1,65 €. Originalpreis 1,93 €.
Hier wird es keine Wunder geben - Edinburgh Art Postkarte
Sale Preis 1,65 €. Originalpreis 1,93 €.
Sri Lanka Buddhistische Tempelansicht Postkarte
Sale Preis 1,88 €. Originalpreis 2,21 €.
Sri Lanka Colombo Tempelansicht Postkarte
Sale Preis 1,88 €. Originalpreis 2,21 €.
Der Mainzer Dom in Rheinland Pfalz Postkarte
Sale Preis 1,65 €. Originalpreis 1,93 €.
Freundschaft, Liebe, Wahrheit Vintag Postkarte
Sale Preis 1,55 €. Originalpreis 1,82 €.
Templar Knight / The crusader / Watercolor Art Postkarte
Sale Preis 1,74 €. Originalpreis 2,04 €.
Das Fürstgebet Postkarte
Sale Preis 1,70 €. Originalpreis 1,99 €.
William Morris Design, All Saints, Postkarte
Sale Preis 1,65 €. Originalpreis 1,93 €.
Matthew 6:34 Bibelverse Postkarte
Sale Preis 1,74 €. Originalpreis 2,04 €.
Vintag Abruzzo Italien Reisen Postkarte
Sale Preis 1,83 €. Originalpreis 2,15 €.
Bezahlung in vollem Rett durch Jesus Karo Christli Postkarte
Sale Preis 1,74 €. Originalpreis 2,04 €.
Steingartenkreuz Postkarte
Sale Preis 1,65 €. Originalpreis 1,93 €.
Ich glaube an Engel T - Shirt und Geschenke Postkarte
Sale Preis 1,74 €. Originalpreis 2,04 €.
Es ist gut mit meinem Soul Notizbuch Dankeskarte
Sale Preis 2,24 €. Originalpreis 3,20 €.
Buddha Mind Postkarte
Sale Preis 1,65 €. Originalpreis 1,93 €.
Christain Cross Artwork Postkarte
Sale Preis 1,70 €. Originalpreis 1,99 €.
Jain Symbol Postkarte
Sale Preis 1,65 €. Originalpreis 1,93 €.
Tarot-Kaiser Postkarte
Sale Preis 1,83 €. Originalpreis 2,15 €.
Göttliche Barmherzigkeit von Kazimierowski Eugene Feiertagspostkarte
Sale Preis 1,45 €. Originalpreis 1,70 €.
Beruf des Glaubens Postkarte
Sale Preis 1,74 €. Originalpreis 2,04 €.
Portrait von Thomas Wolsey (c.1475-1530) Kardinal Postkarte
Sale Preis 1,70 €. Originalpreis 1,99 €.
Golden Stupa Temple Postkarte
Sale Preis 1,70 €. Originalpreis 1,99 €.
logan utah tag postkarte
Sale Preis 1,70 €. Originalpreis 1,99 €.
St. Michael Archangel Evil Religion Glaubensstifte Postkarte
Sale Preis 2,94 €. Originalpreis 3,45 €.
RASTAFARI FLAG BUTTON RAYS + Ihr Zeichen oder Text Postkarte
Sale Preis 1,74 €. Originalpreis 2,04 €.
gebacken. Puppe. Postkarte
Sale Preis 1,74 €. Originalpreis 2,04 €.
Bischofskirche Postkarte
Sale Preis 1,74 €. Originalpreis 2,04 €.
Christlich Postkarte
Sale Preis 1,74 €. Originalpreis 2,04 €.
Bismillah im Namen Gottes Arabische Kalligraphie Postkarte
Sale Preis 1,55 €. Originalpreis 1,82 €.
Matthew 14:22-23 Jesus Prays von sich selbst durch Postkarte
Sale Preis 1,93 €. Originalpreis 2,27 €.
Afrika, Äthiopien. Kunstwerk zur Darstellung von L Postkarte
Sale Preis 1,70 €. Originalpreis 1,99 €.
Gib' uns Feedback!
Wenn du Hilfe benötigst oder eine Frage an unseren Kundendienst hast, besuche bitte unser Hilfecenter.
Zuletzt angesehene Produkte